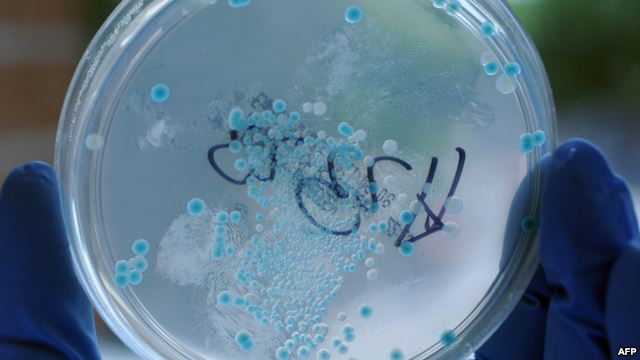

|
Opasna bakterija u bolnicama BiH i Srbije
izvor: bllive , foto: afp 20.06.2015.
Vijest da su, najvjerovatnije od posljedica bakterije Klebsiella pneumonia, u mostarskoj bolnici preminule tri bebe, a u Srbiji dvije odrasle osobe, zabrinula je cijeli region jer je riječ o bakteriji koja je uglavnom otporna na antibiotike, pa u organizmu za relativno kratko vrijeme može da napravi haos.
Klebsiella pneumonia, naime, može da izazove tešku upalu pluća, urinarnog i krvnog sistema, a posebno su ugroženi pacijenti na liječenju u jedinicama intenzivne njege i oni s oslabljenim imunitetom, dok strana tijela poput katetera i drenova povećavaju taj rizik.
Ljekari upozoravaju da Klebsiella pneumonija uzrokuje ubrzano razaranje tkiva u plućima, a osnovni simptom je iznenadna i visoka temperatura u kombinaciji sa vrtoglavicom i groznicom, piše "Press RS".
Obustavljene operacije
Kako je za ovaj list potvrđeno u Institutu za javno zdravstvo, u Srpskoj od početka godine, na sreću, nije bilo prijavljenih oboljelih od ove bakterije.
S druge strane, na Odjeljenju za intenzivno liječenje i neonatologiju Univerzitetsko-kliničke bolnice (UKB) Mostar u proteklih desetak dana preminule su tri bebe, čija se smrt dovodi u vezu s infekcijom bolničkom bakterijom Klebsiella pneumonia.
Tokom jučerašnjeg dana u mostarskom UKB-u novinari nisu uspjeli da saznaju više detalja o pomenutom slučaju. Dan ranije, iz ove zdravstvene ustanove saopštili su da se u bolnici nalazi još jedno dijete koje je na respiratoru, ali da nema razloga za paniku.
"Samo u jednom uzorku nađena je obična, a ne enteropatogena Klebsiella pneumonia. Sve je još na pretpostavkama da se radi o bolničkoj infekciji, a o epidemiji se ne može govoriti", saopštili su iz UKB Mostar.
Kako prenose mediji iz Srbije, takođe se sumnja da su ovom bakterijom bile zaražene i dvije osobe koje su preminule u Urgentnom centru u Beogradu.
Infekcija se, naime, pojavila na Odjeljenju opšte hirurgije, gdje su do daljeg obustavljene sve operacije zbog porasta broja zaraženih.
Iz beogradskog Urgentnog centra saopštili su da je trenutno jedan pacijent u veoma teškom stanju, te da su dvojica smještena na intenzivnu njegu, a dvojica na odjeljenje.
Podsjetimo, u septembru prošle godine u sarajevskoj Klinici za ortopediju Klebsiellom pneumonijom je zaraženo 35 pacijenata, ali bez teže kliničke manifestacije zaraze.
U IJZ objašnjavaju da ova bakterija oboljenja pretežno izaziva kod osoba sa smanjenom odbrambenom sposobnošću.
"Kod zdravih osoba rijetko može uzrokovati infekcije. Kod ljudi bakterije mogu da se nasele na koži, u grlu ili gastrointestinalnom traktu, a mogu "naseliti" i sterilne rane, kao i urin", kaže za Press specijalista epidemiolog u IJZ dr Nina Rodić Vukmir.
Komplikuje liječenje
Ona dodaje da postoji poseban soj ove bakterije koji je otporan na jednu vrstu antibiotika, što komplikuje liječenje ovakvih slučajeva.
"Uzročnik se ne prenosi vazduhom, dok su rezervoar ove bakterije gastrointestinalni trakt i ruke bolničkog osoblja. Može da izazove upalu pluća, infekcije krvi, zapaljenje vena, infekcije urinarnog trakta, zapaljenje žučne kese, infekcije gornjih respiratornih puteva, infekcije rana, zapaljenje kostiju i meningitis2, ističe dr Vukmir.
Iz Svjetske zdravstvene organizacije konstantno upozoravaju da je otpornost bakterija na antibiotike posljedica nekontrolisanog i prekomjernog, veoma često i nepotrebnog, korišćenja ovih lijekova.
Mjere
- higijena ruku je najvažnija mjera
- osoblje u neposrednom radu sa bolesnicima nosi zaštitne pregače, rukavice i zaštitne maske
- ne smije se koristiti nikakav zajednički pribor sa drugim bolesnicima (npr. ručnici, četke za kosu, toplomjer)
- okolina bolesnika mora se svakodnevno održavati čistom i suvom
- bolesnik mora biti smješten u zasebnoj sobi sa zasebnim sanitarnim čvorom da bi se spriječilo širenje bakterije na druge bolesnike
|